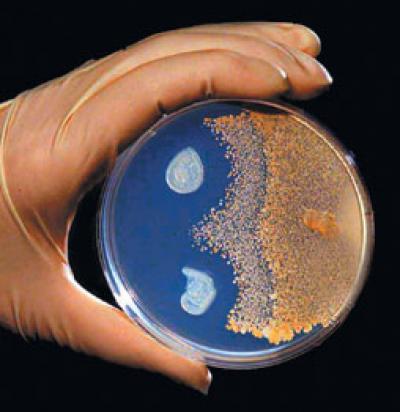

By Kalwinder KaurAug 28 2012
In order to evaluate the real-world performance efficiency of new sensors that were recently developed to identify biological agents, the Department of Homeland Security's Science and Technology Directorate (DHS S&T) has planned a series of tests in the Boston subways.
In late August 2012, an inert form of a naturally occurring innocuous bacterium will be released in select Boston subway stations to test new sensors.
In late August 2012, an inert form of a naturally occurring innocuous bacterium will be released in select Boston subway stations to test new sensors.
S&T's "Detect-to-Protect" (D2P) Bio Detection project is evaluating several sensors to alert authorities about the existence of biological material. With "trigger" and "confirmer" sensors, these devices have been developed for rapidly detecting and confirming the discharge of biological agents.
Followed by the 2009 release, the inert gasses were again released earlier this month in the Boston subway system on behalf of an initial study for confirming the movement of released particulates across the subway network, followed by finding the right location to place the new sensors. The current study focuses on the release of small quantities of an innocuous killed bacterium in Boston’s subway stations to validate the function of sensors.
After the closing hours of subway stations, the subway tunnels will have some amount of killed Bacillus subtilis sprayed over by S&T researchers. This food-grade bacterium is omnipresent and is believed to be nontoxic to plants, humans, and animals.
DHS carries out federal efforts to create an effective solution as a remedy for domestic biological attack. The testing will take place on a regular basis for six subsequent months. The Massachusetts Bay Transportation Authority and state and local public health officials will monitor and track the tests.
The particles released in the stations will rapidly scatter. Prior to being dissipated, the particles and their impacts while under movement will deliver an invaluable data, supporting DHS' continuing initiative to keep American travelers safe from potential hazards.
Disclaimer: The views expressed here are those of the author expressed in their private capacity and do not necessarily represent the views of AZoM.com Limited T/A AZoNetwork the owner and operator of this website. This disclaimer forms part of the Terms and conditions of use of this website.